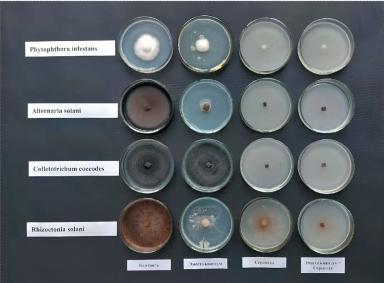
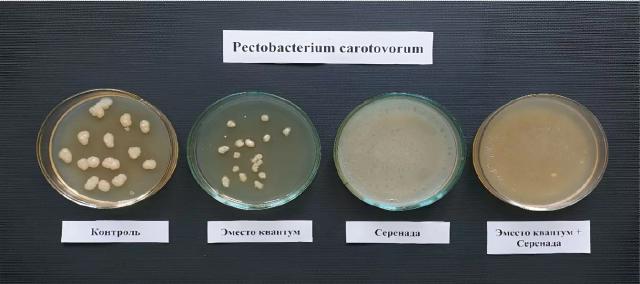

Дорогие друзья!
В рубрике «Вредный объект? У «Августа» ответ!» о сорняке дескурайния Софии и эффективном против него в посевах зерновых гербициде Сахара ® рассказывает Ал ...
Современное растениеводство требует не только полноценного обеспечения культур элементами питания, но и высокой эффективности их усвоения. Даже при достаточном уровне макро- и ...
📝 ЧИЗЕЛЬНЫЙ ПЛУГ УНИВЕРСАЛЬНЫЙ (ПЧУ) – это не просто глубокорыхлитель, а многофункциональный агрегат, совмещающий функции культиватора и глубокорыхлителя в одной машине. В отличие от классических ...
Введение: Вызовы современной гербицидной защиты
Контроль сорной растительности — критический этап в производстве сахарной свёклы. Традиционные схемы защиты решают этот вопрос трёх- и четырёхкратными обработками посевов комплексными баковыми ...
Холдинг «АГРОСИЛА» расширяет линейку сыров в слайсах: на полках появятся «Конбер», «Чеддер» и молодой «Пармезан»
Холдинг «АГРОСИЛА» расширяет ассортимент сыров в нарезке: в 2026 году линейка полутвёрдых ...
Дорогие друзья!
Теперь у «Августа» есть канал и в MAX ! Вы найдете его
Читайте наши публикации там, где вам удобно и ...
Рассказывает начальник отдела развития продуктов «Августа» Владимир Барков:
«Сетчатая пятнистость ячменя – одно из наиболее опасных заболеваний. Его возбудитель – несовершенный гриб Drechslera teres (телеоморфа: Pyrenophora ...
В современных технологиях возделывания сельскохозяйственных культур всё большее значение имеет не только количество вносимых элементов питания, но и форма, в которой они поступают в растение. Для агронома важно не ...
Мировые цены на растительные масла продолжают расти, подтягивая за собой стоимость подсолнечника. Основная причина — удорожание нефти и рост спроса на биотопливо.
Переработчики уже фиксируют повышение закупочных цен ...
🔵 РЕВИСОЛ ® — это инновационная молекула с уникальными особенностями механизма действия. Она точно адаптируется к целевому патогену, обеспечивает быстрое начало действия и стабильную защиту. Именно поэтому ...
Людям, которые живут и работают за городом, развивают агротуризм или ведут фермерское хозяйство, важно грамотно организовать территорию . Для создания комфортной среды можно пригласить ландшафтного дизайнера или ...
- Многополярная открытость и коллективное лидерство. Баланс конкуренции и сотрудничества на ...
Кукуруза проходит более десяти стадий развития. В каждой есть особенности, которые влияют на будущий урожай. В статье расскажем об основных фазах развития гибридов и поделимся практическими советами, которые помогут ...
- Прирост вклада АПК в ВВП на 15-20% к 2030г.
- Увеличение производительности труда в 2-2,5 раза.
- ...
По данным Института аграрных исследований ВШЭ.
Российский ...
- Центр - 14'000 - 14'300 (-200)
- Юг - 16'900 - 17'200 ...
Или, например, Лонтрел.
Возьму на себя смелость предположить, что никак.
Конкурсные закупки? Здорово, но всё равно же — среди тех, кого уже знаете. Рынок за забором остаётся ...
У меня в записной книжке есть пара проверенных временем приемов:
Доезжайте до соседа ...
Квикстеп® – комбинированный системный гербицид для борьбы со злаковыми сорняками в посевах сахарной свеклы, сои, подсолнечника, рапса и других широколиственных культур. В его составе – уникальное сочетание двух д. ...

